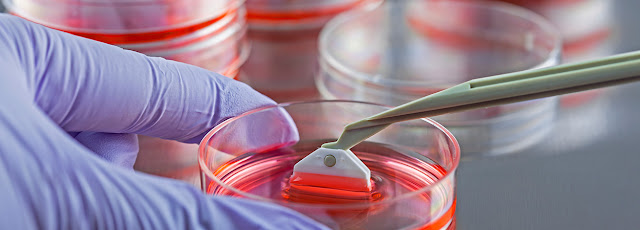

Global microdermabrasion devices market estimated to reach a value of US$481.09 Mn by 2022

Microdermabrasion Devices Market Market Overview: The global microdermabrasion devices market is estimated to reach a value of US$481.09 Mn by 2022 and is projected to grow at a CAGR of 8.0% during the forecast period of 2023-2030. Microdermabrasion devices are widely used in the skincare industry to exfoliate and rejuvenate the skin. These devices help in removing dead skin cells, reducing the appearance of scars and wrinkles, and improving overall skin texture. The increasing demand for non-invasive cosmetic procedures, a growing emphasis on personal grooming and skincare routines, and advancements in technology are driving the market growth. The rising awareness regarding skincare and the desire for youthful and healthy-looking skin are also contributing to the market growth. Market Key Trends: One key trend in the microdermabrasion devices market is the increasing adoption of at-home microdermabrasion devices. With the busy lifestyles and the need for convenient skincare solutions...